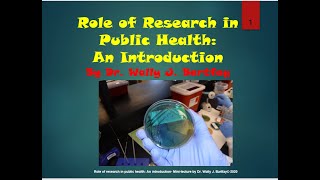
Role of Research in Public Health: An Introduction- mini lecture
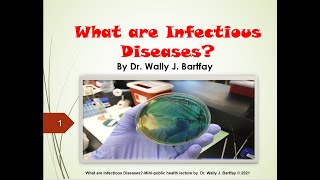
What are infectious diseases?  Mini public health lecture by Dr. Wally J. Bartfay (c) 2021

Dr. Wally Bartfay Lectures in the Health Sciences
@wallybartfay5102 - 27 本の動画
チャンネル登録者数 663人
This site provides a series of health sciences lectures presented by Dr. Wally Bartfay. Topics range from epidemiology; environmental and occupational health...
最近の動画
 2:11
2:11
Best Advice in Life Ever
 7:28
7:28
Essential Equipment for the Solo Indie Music Artist on a Budget
 5:06
5:06
2021 Virtual Graduation Ontario Tech University FHSc
 23:54
23:54
What are noncommunicable diseases? By Dr. Wally J. Bartfay (c) 2021
 36:17
36:17
What are infectious diseases? Mini public health lecture by Dr. Wally J. Bartfay (c) 2021
 18:48
18:48
Neurological Disorders Part II- By Dr. Wally J. Bartfay (c) 2021
 16:06
16:06
Neurological Disorders Part 1-By Dr. Wally J. Bartfay (c) 2021
 31:49
31:49
Mental health: A primer. Mini-public health lecture by Dr. Wally J. Bartfay (c) 2021
 33:53
33:53
What is Global Health? Mini-public health lecture by Dr. Wally J. Bartfay (c) 2021
 21:17
21:17
What is Environmental Health? Mini-public health lecture by Dr. Wally J. Bartfay
 21:27
21:27
What is illness, sickness and disease? Public health mini-lecture by Dr. Wally J. Bartfay
 5:59
5:59
How music can benefit patients with dementia.
 47:11
47:11
Role of Epidemiology in Public Health- Part II
 32:58
32:58
Role of Epidemiology in Public Health-Part 1
34:07
34:07
Role of Research in Public Health: An Introduction- mini lecture
 26:10
26:10
Indigenous Health in Canada-Mini Lecture by Dr. Wally J. Bartfay
 29:53
29:53
Canada's Health Care Systems and Medicare Mini lecture
 14:54
14:54
Creation of a Clinical Demonstration Unit for Dementia
 2:27
2:27
Virtual Graduation Speech 2020 by Dr. Wally J. Bartfay
 4:00
4:00
The role of public health in managing outbreaks and pandemics
 3:55
3:55
Open House Faculty of Health Sciences BAHSc and BHSc programs
 54:59
54:59
Living with Dementia: Challenges for staff and caregivers
 35:36
35:36
The evolving definition of health: A holistic perspective.
 34:31
34:31
Program planning, implementation and evaluation in public health.
 40:46
40:46
The 15 Social Determinants of Health
 18:25
18:25
Health promotion and the 5 levels of prevention
 33:37
33:37
What is public health exactly?
動画
36:17
36:17
What are infectious diseases? Mini public health lecture by Dr. Wally J. Bartfay (c) 2021
1003 回視聴 - 4 年前
 31:49
31:49
Mental health: A primer. Mini-public health lecture by Dr. Wally J. Bartfay (c) 2021
563 回視聴 - 4 年前
 33:53
33:53
What is Global Health? Mini-public health lecture by Dr. Wally J. Bartfay (c) 2021
3516 回視聴 - 4 年前
 21:17
21:17
What is Environmental Health? Mini-public health lecture by Dr. Wally J. Bartfay
3343 回視聴 - 4 年前
 21:27
21:27
What is illness, sickness and disease? Public health mini-lecture by Dr. Wally J. Bartfay
1.3万 回視聴 - 4 年前